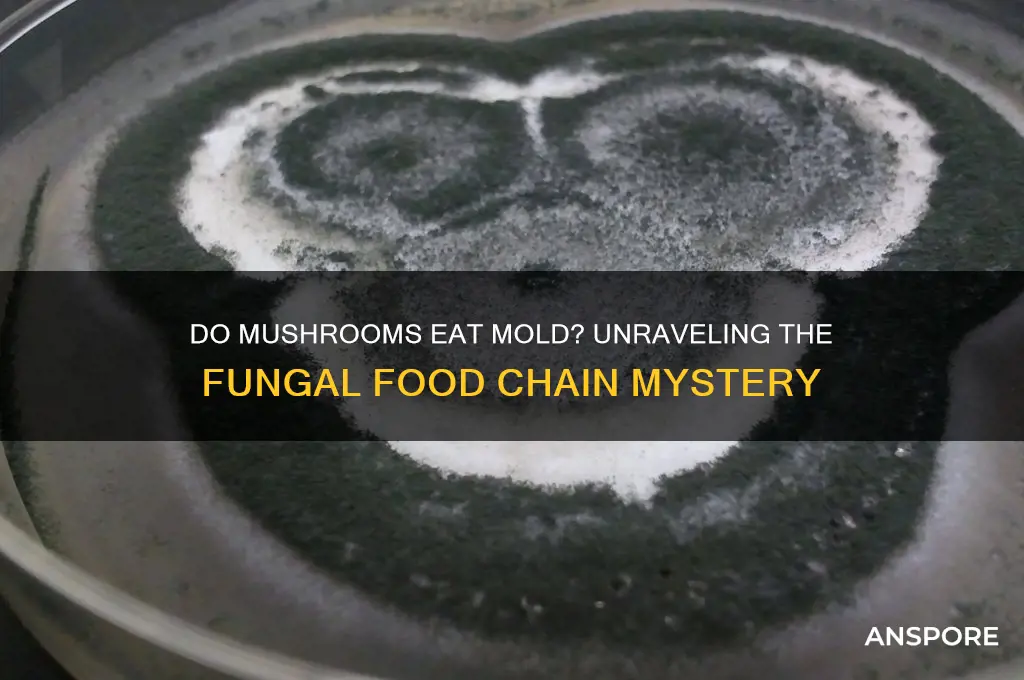
does a mushroom eat mold

Mushrooms and mold are both fungi, but their roles in ecosystems and their interactions with each other are often misunderstood. While mushrooms are typically decomposers that break down organic matter like wood and leaves, mold thrives on simpler organic materials such as bread or damp surfaces. The question of whether a mushroom eats mold is intriguing, as it delves into the complex relationships within the fungal kingdom. Mushrooms do not directly consume mold in the way animals eat food; instead, they may compete with mold for resources or even inhibit its growth through chemical interactions. Understanding this dynamic sheds light on the intricate balance of microbial life and the ways fungi coexist or compete in their environments.
| Characteristics | Values |
|---|---|
| Mushrooms and Mold Interaction | Mushrooms do not "eat" mold in the traditional sense. Instead, they compete with mold for resources. |
| Decomposition Role | Mushrooms are decomposers, breaking down organic matter like wood, leaves, and dead organisms. |
| Mold Competition | Both mushrooms and mold are fungi, often competing for the same nutrients in their environment. |
| Mycelium vs. Mold | Mushroom mycelium can sometimes outcompete mold by growing faster and consuming available resources first. |
| Antifungal Properties | Some mushrooms produce compounds that inhibit mold growth, indirectly reducing mold presence. |
| Ecological Niche | Mushrooms and mold occupy similar ecological niches but have different growth strategies and resource utilization. |
| Human Use | Mushrooms are cultivated for food and medicine, while mold is often seen as a contaminant, though some molds are used in food production (e.g., cheese, penicillin). |
| Growth Conditions | Both thrive in damp, organic-rich environments but have distinct optimal conditions for growth. |
| Symbiotic Relationships | Mushrooms can form symbiotic relationships with plants (mycorrhiza), while mold typically does not. |
| Impact on Food | Mushrooms are edible and beneficial, whereas mold on food is usually a sign of spoilage and can be harmful. |
Explore related products
$13.48 $14.13
What You'll Learn
- Mushroom Nutrition Sources: Mushrooms absorb nutrients from decaying matter, not by eating mold directly
- Mycelium vs. Mold: Mycelium networks compete with mold for resources in their environment
- Decomposer Role: Mushrooms break down organic material, including mold, as part of decomposition
- Symbiotic Relationships: Some mushrooms form relationships with organisms that inhibit mold growth
- Mold as Competitor: Mold and mushrooms often compete for the same food sources in ecosystems

Mushroom Nutrition Sources: Mushrooms absorb nutrients from decaying matter, not by eating mold directly
Mushrooms are fascinating organisms that play a crucial role in ecosystems as decomposers. Unlike plants, which produce their own food through photosynthesis, mushrooms obtain nutrients by breaking down organic matter. This process is often misunderstood, leading to the common question: "Do mushrooms eat mold?" The answer lies in understanding how mushrooms actually acquire their nutrition. Mushrooms do not "eat" mold or any other organism directly. Instead, they absorb nutrients from decaying organic material, such as dead plants, wood, and other substrates, through a network of thread-like structures called mycelium.
The mycelium of a mushroom secretes enzymes that break down complex organic compounds—like cellulose, lignin, and chitin—into simpler forms that the fungus can absorb. This process is known as extracellular digestion. While mold (a type of fungus) and mushrooms both thrive on decaying matter, mushrooms do not consume mold as a food source. Instead, they coexist in similar environments, each breaking down organic material independently. Mushrooms are particularly efficient at extracting nutrients from substrates that are difficult for other organisms to decompose, making them vital for nutrient cycling in ecosystems.
It’s important to clarify that mushrooms are not predators or consumers in the traditional sense. They are saprotrophic organisms, meaning they derive nutrients from non-living organic matter. This distinguishes them from parasitic or mycorrhizal fungi, which form symbiotic relationships with living plants. The misconception that mushrooms "eat mold" likely stems from observing both fungi growing on the same decaying material, but their nutritional strategies are distinct. Mushrooms focus on breaking down dead matter, while mold often colonizes living or recently deceased organic material.
The nutrient absorption process of mushrooms is highly efficient and specialized. As the mycelium grows through the substrate, it releases enzymes tailored to the specific compounds present, such as proteins, carbohydrates, and fats. These enzymes break down the material into amino acids, simple sugars, and fatty acids, which the mushroom then absorbs. This mechanism allows mushrooms to thrive in environments rich in decaying matter, such as forests, where they contribute to the breakdown of fallen trees and leaf litter.
In summary, mushrooms do not eat mold or any other organism directly. Their nutrition comes from absorbing nutrients from decaying organic matter through their mycelium. This process highlights their role as decomposers, breaking down complex materials into simpler forms that can re-enter the ecosystem. Understanding this distinction is key to appreciating the unique and essential function of mushrooms in nature. By clarifying this misconception, we can better recognize the importance of mushrooms in nutrient cycling and their contribution to healthy ecosystems.
Do Apes Eat Mushrooms? Exploring Primate Fungal Consumption Habits
You may want to see also

Mycelium vs. Mold: Mycelium networks compete with mold for resources in their environment
In the intricate world of fungi, the relationship between mycelium and mold is both competitive and ecologically significant. Mycelium, the vegetative part of a fungus consisting of a network of fine white filaments called hyphae, plays a crucial role in nutrient cycling and ecosystem health. Mold, on the other hand, is a type of fungus that grows in multicellular, thread-like structures and is often associated with decomposition and spoilage. Both mycelium and mold rely on the same environmental resources, such as organic matter, moisture, and space, which sets the stage for direct competition between these two fungal entities.
Mycelium networks are highly efficient at colonizing substrates, secreting enzymes to break down complex organic materials into simpler nutrients. This process not only supports the growth of the fungus but also enhances soil fertility and promotes plant health. Mold, while also capable of breaking down organic matter, often thrives in environments with high humidity and stagnant air, such as on food or damp surfaces. When mycelium and mold coexist in the same environment, the mycelium's extensive network gives it a competitive edge in absorbing nutrients and water, effectively outcompeting mold for these limited resources.
The competition between mycelium and mold is further intensified by their differing growth strategies. Mycelium networks expand rapidly, forming dense mats that can physically exclude mold from colonizing the same area. Additionally, some mycelium species produce antimicrobial compounds that inhibit mold growth, further tipping the balance in their favor. This competitive advantage is particularly evident in environments like forests, where mycelium networks dominate the soil and wood substrates, leaving little room for mold to establish itself.
From an ecological perspective, the dominance of mycelium over mold has significant implications. Mycelium's ability to outcompete mold contributes to the suppression of harmful mold species that could otherwise degrade food, damage structures, or produce allergens. Furthermore, mycelium's role in nutrient cycling and soil health supports biodiversity and ecosystem resilience. By understanding this competitive dynamic, we can harness the power of mycelium networks in applications such as bioremediation, sustainable agriculture, and even mold control in indoor environments.
In the context of whether mushrooms "eat" mold, it’s more accurate to say that mycelium networks compete with and suppress mold rather than consuming it directly. While mycelium does break down organic matter, including materials that mold might colonize, the interaction is primarily one of resource competition and territorial exclusion. This distinction highlights the complex and often antagonistic relationships within the fungal kingdom, where mycelium emerges as a key player in shaping microbial communities and maintaining ecological balance. By fostering mycelium growth, we can indirectly mitigate mold proliferation, leveraging nature’s own mechanisms to create healthier environments.
Raw Mushrooms: Safe to Eat or Risky Culinary Adventure?
You may want to see also

Decomposer Role: Mushrooms break down organic material, including mold, as part of decomposition
Mushrooms play a crucial decomposer role in ecosystems by breaking down organic material, including mold, as part of the natural decomposition process. Unlike plants, which produce their own food through photosynthesis, mushrooms are heterotrophs, meaning they obtain nutrients by absorbing organic matter from their environment. This process is essential for nutrient cycling, as mushrooms help return vital elements like carbon and nitrogen back into the soil, supporting plant growth and maintaining ecological balance. Their ability to decompose a wide range of organic materials, including mold, makes them key players in the breakdown of complex substances into simpler forms.
The decomposition process begins when mushrooms secrete enzymes into their surroundings. These enzymes break down complex organic compounds, such as cellulose, lignin, and chitin, into smaller, more manageable molecules. Mold, which is a type of fungus itself, consists of organic matter that mushrooms can readily target. As mushrooms "eat" mold, they absorb the nutrients released during the breakdown process, effectively recycling the organic material. This action not only eliminates mold but also prevents the accumulation of dead organic matter, reducing the risk of disease and promoting a healthier environment.
Mushrooms' decomposer role is particularly important in environments where mold thrives, such as damp, decaying wood or plant debris. By breaking down mold, mushrooms limit its spread and prevent it from dominating ecosystems. This is especially beneficial in forests, where fallen trees and leaves provide ample substrate for both mold and mushrooms. The competitive relationship between mushrooms and mold ensures that neither organism overpowers the other, maintaining a balance that supports biodiversity and ecosystem health.
In addition to their direct role in decomposing mold, mushrooms contribute to overall soil health by improving its structure and fertility. As they break down organic material, they create pores in the soil, enhancing aeration and water retention. This, in turn, fosters a more favorable environment for other decomposers, such as bacteria and insects, to thrive. The collaborative effort of these organisms ensures that organic matter, including mold, is efficiently broken down and recycled, sustaining the nutrient cycle.
Understanding the decomposer role of mushrooms highlights their ecological significance beyond their culinary or medicinal uses. By breaking down organic material, including mold, mushrooms act as nature's recyclers, transforming waste into resources. This process not only supports the growth of new life but also underscores the interconnectedness of organisms in ecosystems. Thus, mushrooms are not just passive participants in decomposition; they are active agents that drive the renewal of organic matter, ensuring the continuity of life on Earth.
Can Worms Safely Consume Poisonous Mushrooms? Unveiling the Truth
You may want to see also
Explore related products
$25.95 $33.98

Symbiotic Relationships: Some mushrooms form relationships with organisms that inhibit mold growth
Mushrooms do not directly "eat" mold in the way animals consume food, but they can play a significant role in inhibiting mold growth through symbiotic relationships with other organisms. These relationships are often mutualistic, meaning both parties benefit. For instance, certain mushrooms form associations with bacteria or other microorganisms that produce antifungal compounds. These compounds suppress mold growth, creating a more favorable environment for the mushroom to thrive. This indirect mechanism highlights how mushrooms can contribute to mold inhibition without directly consuming it.
One notable example of such a symbiotic relationship is between mycorrhizal fungi and plant roots. Mycorrhizal mushrooms form a network with plant roots, enhancing nutrient uptake for the plant while receiving carbohydrates in return. This association strengthens the plant's immune system, making it more resistant to mold and other pathogens. Additionally, the fungal network can outcompete mold for resources, further reducing mold growth in the surrounding soil. This mutualistic relationship demonstrates how mushrooms can indirectly inhibit mold while supporting plant health.
Another example involves mushrooms that partner with specific bacteria or yeasts. Some bacteria produce volatile organic compounds (VOCs) or antibiotics that are toxic to mold. When mushrooms coexist with these bacteria, they benefit from the mold-inhibiting properties of these compounds. In return, the mushrooms may provide the bacteria with a stable habitat or nutrients, fostering a symbiotic relationship. This collaboration is particularly effective in environments like soil or decaying wood, where mold competition is high.
In agricultural settings, farmers and researchers are exploring these symbiotic relationships to develop natural mold control methods. For instance, introducing beneficial mushrooms or their associated microorganisms to crops can reduce the need for chemical fungicides. This approach not only inhibits mold growth but also promotes sustainable farming practices. By understanding and harnessing these relationships, we can leverage mushrooms as allies in maintaining mold-free environments.
Lastly, the role of mushrooms in inhibiting mold extends to their ecological function as decomposers. While breaking down organic matter, mushrooms often compete with mold for resources. In some cases, mushrooms dominate the substrate, leaving little room for mold to establish itself. This competitive exclusion is another way mushrooms indirectly control mold growth. Combined with their symbiotic relationships, mushrooms emerge as key players in maintaining microbial balance in ecosystems.
Can Eating Mushrooms Lead to Stomach Pumping? Facts Revealed
You may want to see also

Mold as Competitor: Mold and mushrooms often compete for the same food sources in ecosystems
In the intricate web of ecosystems, mold and mushrooms often find themselves in direct competition for the same food sources. Both organisms are saprotrophs, meaning they obtain nutrients by breaking down organic matter such as dead plants, wood, and other decaying material. This shared reliance on decomposing organic material sets the stage for a natural rivalry, as resources are finite and both mold and mushrooms require them to grow and reproduce. While mushrooms are the visible fruiting bodies of fungi, mold represents the filamentous growth of certain fungi, and their overlapping dietary needs make them competitors in the same ecological niche.
Mold typically colonizes substrates more rapidly than mushrooms due to its fast-growing, thread-like structures called hyphae. This speed allows mold to quickly dominate a food source, leaving fewer nutrients available for mushrooms. For example, in a damp wooden log, mold may establish itself first, consuming cellulose and lignin before mushrooms can fully develop. This competitive advantage is particularly significant in environments where resources are scarce or where conditions favor the quicker growth of mold, such as in highly humid or nutrient-poor settings.
Despite their competition, the relationship between mold and mushrooms is not always zero-sum. In some cases, their activities can complement each other in the decomposition process. Mold often breaks down complex organic materials into simpler compounds, which can then be more easily absorbed by mushrooms. However, this dynamic does not eliminate the competitive aspect, as both still require the same end resources to thrive. The balance between cooperation and competition depends on environmental factors, such as moisture levels, temperature, and the availability of organic matter.
Mushrooms, with their more complex structures and slower growth rates, have evolved strategies to mitigate mold competition. Some mushroom species produce antifungal compounds that inhibit mold growth, giving them an edge in resource acquisition. Additionally, mushrooms often grow in specific microhabitats where mold is less prevalent, such as deeper within wood or soil, where conditions may be less favorable for mold. These adaptations highlight the evolutionary pressures imposed by mold as a competitor and underscore the ongoing struggle for dominance in shared ecosystems.
Understanding the competitive dynamics between mold and mushrooms is crucial for fields like ecology, agriculture, and mycology. For instance, in agricultural settings, mold can outcompete beneficial mushrooms, leading to crop losses or reduced soil health. Conversely, promoting mushroom growth can sometimes suppress mold, as seen in certain biocontrol strategies. By studying these interactions, scientists can develop methods to manage ecosystems more effectively, ensuring that resources are utilized in ways that support biodiversity and sustainability. In essence, the rivalry between mold and mushrooms is a microcosm of the broader competition for resources that shapes life on Earth.
Are Dried-Out Mushrooms Safe to Eat? A Complete Guide
You may want to see also
Frequently asked questions
Mushrooms do not "eat" mold in the way animals eat food. Instead, mushrooms are decomposers that break down organic matter, including mold, through the secretion of enzymes.
Mushrooms and mold often compete for the same organic resources. Mushrooms can outcompete mold by breaking down materials more efficiently, but they do not consume mold directly.
Yes, mushrooms can grow on moldy surfaces because both thrive on decaying organic matter. However, the presence of mold does not necessarily mean mushrooms will grow there.
Mushrooms and mold often coexist in the same environment, but mushrooms do not directly benefit from mold. Both play roles in decomposition, but their interactions are more about competition than cooperation.
Mold can compete with mushrooms for nutrients, potentially hindering their growth. However, mushrooms are generally more efficient decomposers and can often outcompete mold in the same environment.











































